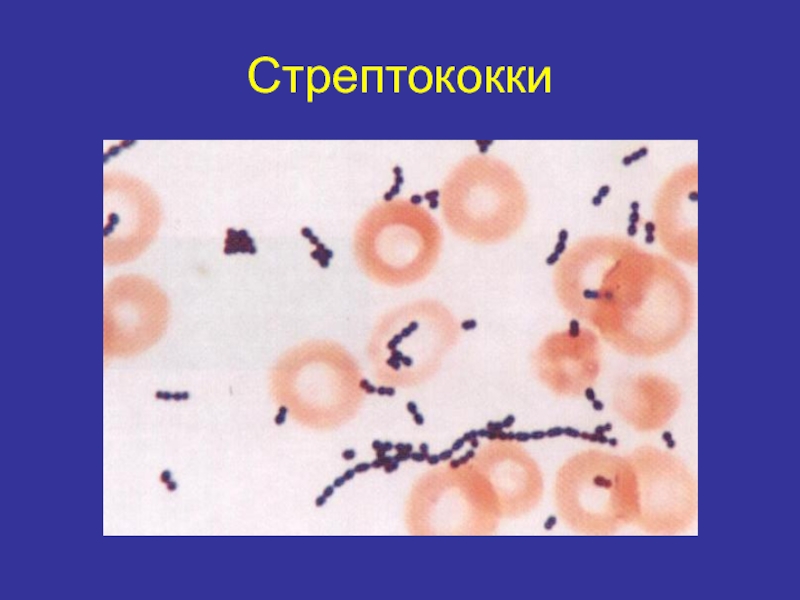
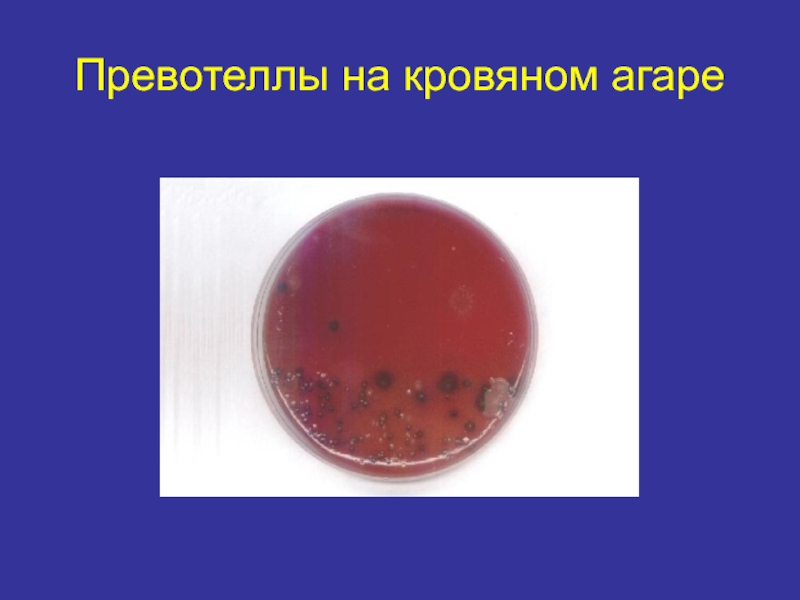
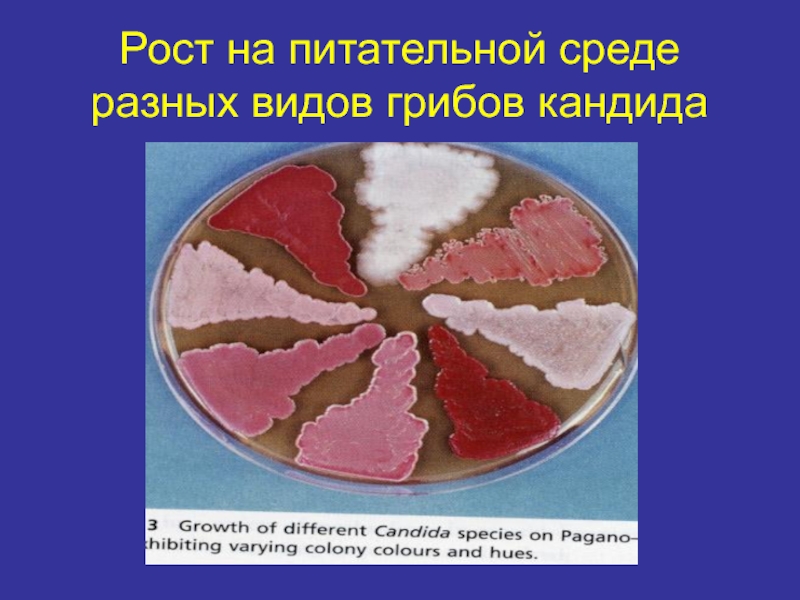

Разделы презентаций
- Разное
- Английский язык
- Астрономия
- Алгебра
- Биология
- География
- Геометрия
- Детские презентации
- Информатика
- История
- Литература
- Математика
- Медицина
- Менеджмент
- Музыка
- МХК
- Немецкий язык
- ОБЖ
- Обществознание
- Окружающий мир
- Педагогика
- Русский язык
- Технология
- Физика
- Философия
- Химия
- Шаблоны, картинки для презентаций
- Экология
- Экономика
- Юриспруденция
Микрофлора полости рта
Содержание
- 1. Микрофлора полости рта
- 2. Основные группы бактерий вегетирующих в полости рта.
- 3. Слайд 3
- 4. Типы дыхания бактерийАнаэробноеАэробноеФакультативно-анаэробное дыхание
- 5. Gram PositiveGram Negative
- 6. The Gram negative cell envelope Covalently linked
- 7. Gram Positive Cell Envelope (Figure 2)Covalently bound
- 8. 1. Эмаль и цемент зубаКислотообразующие микробы:1. Streptococcus
- 9. Электронная микроскопия стрептококков
- 10. Стрептококки
- 11. Гемолиз на кровяном агаре.
- 12. Бета-гемолитические колонии S.milleri на кровяном агаре
- 13. 2. Зубо-десневой желобок Грам-отрицательные бактерии.1. Prevotella melaninogenica2. Fusobacterium spp.Грам-положительные бактерии.1.Peptostreptococcus spp.2.Actinomyces spp.3.Streptococcus sanguis4. Streptococcus intermedius
- 14. Превотеллы на кровяном агаре
- 15. Prevotella bivia
- 16. Мазок из чистой культуры бактероидов
- 17. Препарат из чистой культуры Fusobacteriun nucleatum
- 18. Фузобактерии и спирохеты.
- 19. Фузобактерии (окраска по Граму)
- 20. Фузобактерии на кровяном агаре
- 21. Актиномицеты
- 22. Рост чистой культуры Actinomyces israeli на кровяном агаре.
- 23. Пептострептококки
- 24. Пептострептококки в мазке из гнойного экссудата
- 25. 3. Спинка языка1.Streptococcus salivarius2. Streptococcus sanguis3. Lactobacillus spp.4. Leptotrichia buccalis5. Candida spp.
- 26. Морфология стрептококков
- 27. 4. Лакуны слизистой оболочки полости ртаГрам-положительные бактерии.1.
- 28. Пептострептококки
- 29. Нокардии
- 30. Спирохеты
- 31. Спирохеты. Электронная микроскопия.
- 32. 5. Слизистая оболочка полости ртаГрам-положительные бактерии1. S.sanguis2. S. mitis3. Corynebacterium spp.Грам-отрицательные бактерии1.Veillonella spp.2.Neiseria spp.3.Propionibacterium spp.Дрожжеподобные грибы
- 33. Пропионибактерии
- 34. Коринебактерии
- 35. Дрожжеподобные грибы кандида.
- 36. Candida albicans (окраска по Граму)
- 37. Рост на питательной среде разных видов грибов кандида
- 38. Изолированные колонии Candida albicans и Candida tropicalis на плотной питательной среде.
- 39. Пути распространения одонтогенной инфекции
- 40. Диагностика одонтогенных инфекций
- 41. Слайд 41
- 42. Слайд 42
- 43. Скачать презентанцию
Основные группы бактерий вегетирующих в полости рта.
Слайды и текст этой презентации
Слайд 7Gram Positive Cell Envelope (Figure 2)
Covalently bound to the thick
peptidoglycan are teichoic acid (their backbones are usually phosphorus-containing polymers
of ribitol or glycerol) or teichuronic acid (glucuronic acid- containing polysaccharides). These negatively charged molecules are believed to be involved in concentrating metal ions from the surroundings. Teichoic acids can also direct autolytic enzymes to sites of peptidoglycan digestion (autolysis), one of the steps in cell wall biosynthesis. In some instances neutral polysaccharides are present. Lipoteichoic acid, in many bacteria, is generally associated with the cell membrane. In other instances it occurs in the fimbriae on the outside of the cell. When expressed on the cell exterior it can be involved in adhesion to epithelial cells allowing colonization of the throat (e.g. by the group A streptococcus).Слайд 81. Эмаль и цемент зуба
Кислотообразующие микробы:
1. Streptococcus mutans
2. Actinomyces spp.
3.
Lactobacterium spp.
Микробы-антагонисты:
1. Veillonella alcalescence
2. Veillonella parvula
3. Peptostreptococcus spp.
Слайд 132. Зубо-десневой желобок
Грам-отрицательные бактерии.
1. Prevotella melaninogenica
2. Fusobacterium spp.
Грам-положительные бактерии.
1.Peptostreptococcus
spp.
2.Actinomyces spp.
3.Streptococcus sanguis
4. Streptococcus intermedius
Слайд 253. Спинка языка
1.Streptococcus salivarius
2. Streptococcus sanguis
3. Lactobacillus spp.
4. Leptotrichia buccalis
5.
Candida spp.
Слайд 274. Лакуны слизистой оболочки полости рта
Грам-положительные бактерии.
1. Streptococcus sangus
2. Streptococcus
mitis
3. Peptostreptococcus spp.
4. Nocardia spp.
Грам-отрицательные бактерии.
1. Фузобактерии
2. Лептотрихии
3. Спирохеты
Простейшие и
грибы1. Амебы
2.Трихоманады
3. Дрожжеподобные грибы кандида